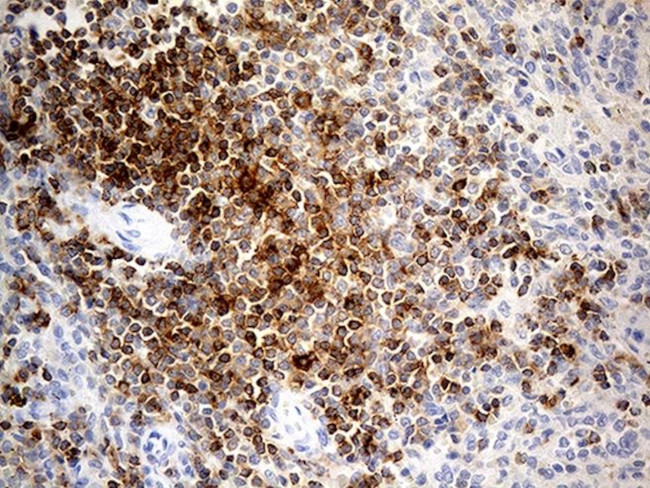
LY9 Antibody in Immunohistochemistry (Paraffin) (IHC (P))

Search
OriGene
LY9 Monoclonal Antibody (OTI2H4), TrueMAB™
{{$productOrderCtrl.translations['antibody.pdp.commerceCard.promotion.promotions']}}
{{$productOrderCtrl.translations['antibody.pdp.commerceCard.promotion.viewpromo']}}
{{$productOrderCtrl.translations['antibody.pdp.commerceCard.promotion.promocode']}}: {{promo.promoCode}} {{promo.promoTitle}} {{promo.promoDescription}}. {{$productOrderCtrl.translations['antibody.pdp.commerceCard.promotion.learnmore']}}
产品信息
CF811828
种属反应
宿主/亚型
分类
类型
克隆号
抗原
偶联物
形式
浓度
规格
纯化类型
保存液
内含物
保存条件
运输条件
产品详细信息
For reconstitution, we recommend adding 100 µL distilled water to a final antibody concentration of about 1 mg/mL. To use this carrier-free antibody for conjugation experiments, we strongly recommend performing another round of desalting. (Zeba Spin Desalting Columns, 7KMWCO, 0.5 mL, Product # 89882)
靶标信息
CD229 (Ly9) is a cell surface receptor of the CD150 family, which includes also e.g. CD48 and CD224. Receptors of this family regulate cytokine production and cytotoxicity of lymphocytes and NK cells. High levels of CD229 are found on T and B cells, where its expression increases during their maturation. It is absent on granulocytes, bone marrow-derived dendritic cells, platelets and erythrocytes. CD229 has been also reported on mouse monocytes and NK cells. CD229 interacts homophilically through its N-terminal domain and localizes to the contact site between T cells and antigen presenting B cells during antigen-dependent immune synapse formation.
仅用于科研。不用于诊断过程。未经明确授权不得转售。
篇参考文献 (0)
生物信息学
蛋白别名: CD229; Cell surface molecule Ly-9; Ly-9; Lymphocyte antigen 9; RP11-312J18.1; Signaling lymphocytic activation molecule 3; similar to Homo sapiens lymphocyte antigen 9 precursor (LY-9) mRNA with GenBank Accession Number AF55709; SLAM family member 3; SLAMF3; T-lymphocyte surface antigen Ly-9; unnamed protein product
基因别名: CD229; CDABP0070; hly9; LY9; mLY9; SLAMF3
UniProt ID: (Human) Q9HBG7
Entrez Gene ID: (Human) 4063